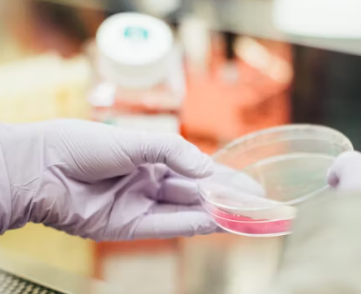
암보험 비교사이트 가격 추천상품

암보험 비교사이트 가격 추천상품 총정리
암보험 필요성



암보험은 암 진단을 받았을 때 정해진 액수를 지급해 치료비와 검사비, 입원비 등으로 사용할 수 있게 해 주는 보험입니다. 통계청 자료에 따르면 우리 국민 3명 중 1명은 평생 한 번쯤 암을 겪습니다. 암은 우리 국민의 사망 원인 중 부동의 1위이기도 하며, 큰 질병에 걸릴 경우 치료비 외에도 생활비, 간병비 등 목돈이 들기 때문에 실손보험만으로는 부족하므로 암 보험에 가입해 치료비를 준비하는 것이 좋습니다.
또한, 암 보험은 젊고 건강할 때 가입하는 것이 중요합니다. 나이가 들면 보장이 줄고 보험료가 오르기 때문입니다. 유전력이 있는 경우에는 가능한 빠르게 가입하는 것이 좋습니다.
암보험 비교사이트

암보험 비교사이트로는 보험다모아, 보험프라자, 아이보험 등이 있습니다.
보험다모아는 다양한 보험사의 암 보험 상품들을 한눈에 비교할 수 있는 사이트이며, 보험프라자는 암보험을 포함한 다양한 보험 상품을 비교하는 데 특화된 사이트입니다. 아이보험은 특히 보장 분석 도구를 통해 자신에게 필요한 보장 항목을 추천받을 수 있습니다.
암보험비교사이트를 이용할 때는 보장 범위, 특정 암 보장 여부, 보험료 등을 고려하여 자신에게 맞는 최적의 보험을 선택하는 것이 중요합니다. 또한, 다른 가입자들의 리뷰나 평가를 통해 보험사들의 신뢰도와 평판을 확인하는 것도 도움이 될 수 있습니다.
암보험 가격
암보험 가격은 보험사, 보장 내용, 갱신 여부, 환급금 지급 여부 등에 따라 다르기 때문에 정확한 가격을 말씀드리기는 어렵습니다. 다만, 일반적으로 암보험의 가격은 1만 원 ∼ 10만 원 사이로 형성되어 있으며, 개인의 상황에 따라 적합한 보험을 선택하는 것이 중요합니다.
보험 가입 전에는 반드시 보장 내용과 보험료를 꼼꼼히 비교해 보고, 자신에게 맞는 최적의 보험을 선택하는 것이 중요합니다. 이를 위해서는 암보험 비교사이트를 이용하거나 전문가의 조언을 듣는 것도 좋은 방법입니다.
암보험 추천상품



삼성화재 암보험
삼성화재는 고객의 건강한 삶을 지키는 다양한 보험 상품을 제공하고 있으며 그중에서도 삼성화재 암보험은 암 진단 시 요양비, 특약비 등을 보장해 준다는 점에서 중요합니다.
삼성화재 암보험은 암 진단 시 기본 약정금액을 지급하고, 수술 시 추가로 비용을 보장하는 제도를 가지고 있습니다. 더불어, 특정 암 진단 시에는 추가로 약정금액의 일부를 지원해 주는 혜택도 포함되어 있어, 암으로 인한 경제적 부담을 완화할 수 있습니다. 자세한 사항은 삼성화재 홈페이지에서 확인하실 수 있습니다.
현대해상 암보험
현대해상 암보험의 장점은 다음과 같습니다.
- 다양한 보장 내용
암 진단비, 입원비, 수술비, 방사선 및 항암치료비로 다양한 보장 내용을 갖춘 현대해상 계속 받는 암보험은 암 환자에게 종합적인 경제적 지원을 제공합니다.
- 추가 서비스
현대해상 계속받는 암보험은 암 환자를 위한 다양한 서비스를 제공합니다. 전문가 상담, 가사도우미 서비스, 통증 완화 치료, 그리고 재활치료 등이 그 예입니다. 더불어 CT 검사, PET 검사 등의 검사도 제공되어 암 환자와 가족들의 건강관리에 큰 도움을 줍니다.
- 계속되는 보장
암 진단 이후에도 계속되는 보장과 다양한 서비스를 통해 암 환자의 건강과 복지를 종합적으로 지원합니다.
우체국 암보험



우체국 암보험의 장점은 다음과 같습니다.
- 저렴한 보험료
저렴한 보험료로 인해 많은 사람들에게 인기가 있는 보험상품입니다.
- 다양한 암 진단에 대한 보장
고액암은 6천만 원, 일반암 3천만 원, 기타 암 300만 원까지 보장되며, 면책기간은 2년입니다.
- 보험금 분할 지급
암에 대한 보험금이 일시적으로 지급되는 것이 아니라, 특정 기간 동안 분할하여 지급된다는 점이 특징입니다. 이로 인해 보험금을 일시에 모두 사용하지 않고, 치료 기간 동안 필요한 비용을 체계적으로 준비해 둘 수 있습니다.
암보험 가입할 때 고려해야 하는 것
암보험 상품을 선택할 때에는 여러 가지 요소를 주의 깊게 살펴봐야 합니다.
보험 상품의 보장 내용, 보험금 청구 절차, 가입 나이 제한, 보험료 납입 방법 등을 꼼꼼히 살펴보는 것이 필요합니다. 암보험 추천 사이트 암보험 상품을 이용하려면 자신의 건강 상태를 정확히 파악해야 합니다. 각 보험사마다 상품의 특징과 보장 내용이 다를 수 있기 때문에 비교 분석이 필요합니다. 암보험은 특히 예방력이 강화되면서 많은 보험사들이 다양한 혜택을 제공하고 있습니다.
암보험 상품 가입 사이트 보험 가입 동기나 상황에 따라 적합한 보상금을 선택하는 것이 중요합니다. 암보험 상품을 비교할 때에는 각 상품의 보장 범위와 보험 가입 나이, 가입 기간, 납입 기간, 보험료 등을 고려해야 합니다. 이를 통해 자신에게 알맞은 암보험 상품을 찾을 수 있을 것입니다.
암보험 비갱신형이란
암보험 비갱신형은 보험료가 처음 가입했을 때 정한 그대로 오르지 않고 보험계약이 끝날 때까지 유지되는 상품입니다. 암보험 비갱신형은 초기 보험료가 갱신형에 비해 비싸지만, 보험료 변동이 없어 장기적으로 보았을 때 더 안정적인 보장을 받을 수 있다는 장점이 있습니다. 반면 암보험 갱신형은 일정 주기마다 보험료가 변동되는 상품입니다. 보험료가 저렴하다는 장점이 있으나, 갱신 주기마다 보험료가 오를 수 있고, 보험계약이 갱신되지 않을 수도 있다는 단점이 있습니다.
따라서 암보험을 선택할 때는 자신의 상황과 선호도에 따라 비갱신형과 갱신형 중 선택하는 것이 중요합니다. 또, 보험료와 보장 내용 등을 꼼꼼히 비교하여 자신에게 맞는 최적의 암보험을 선택하는 것이 필요합니다.


댓글